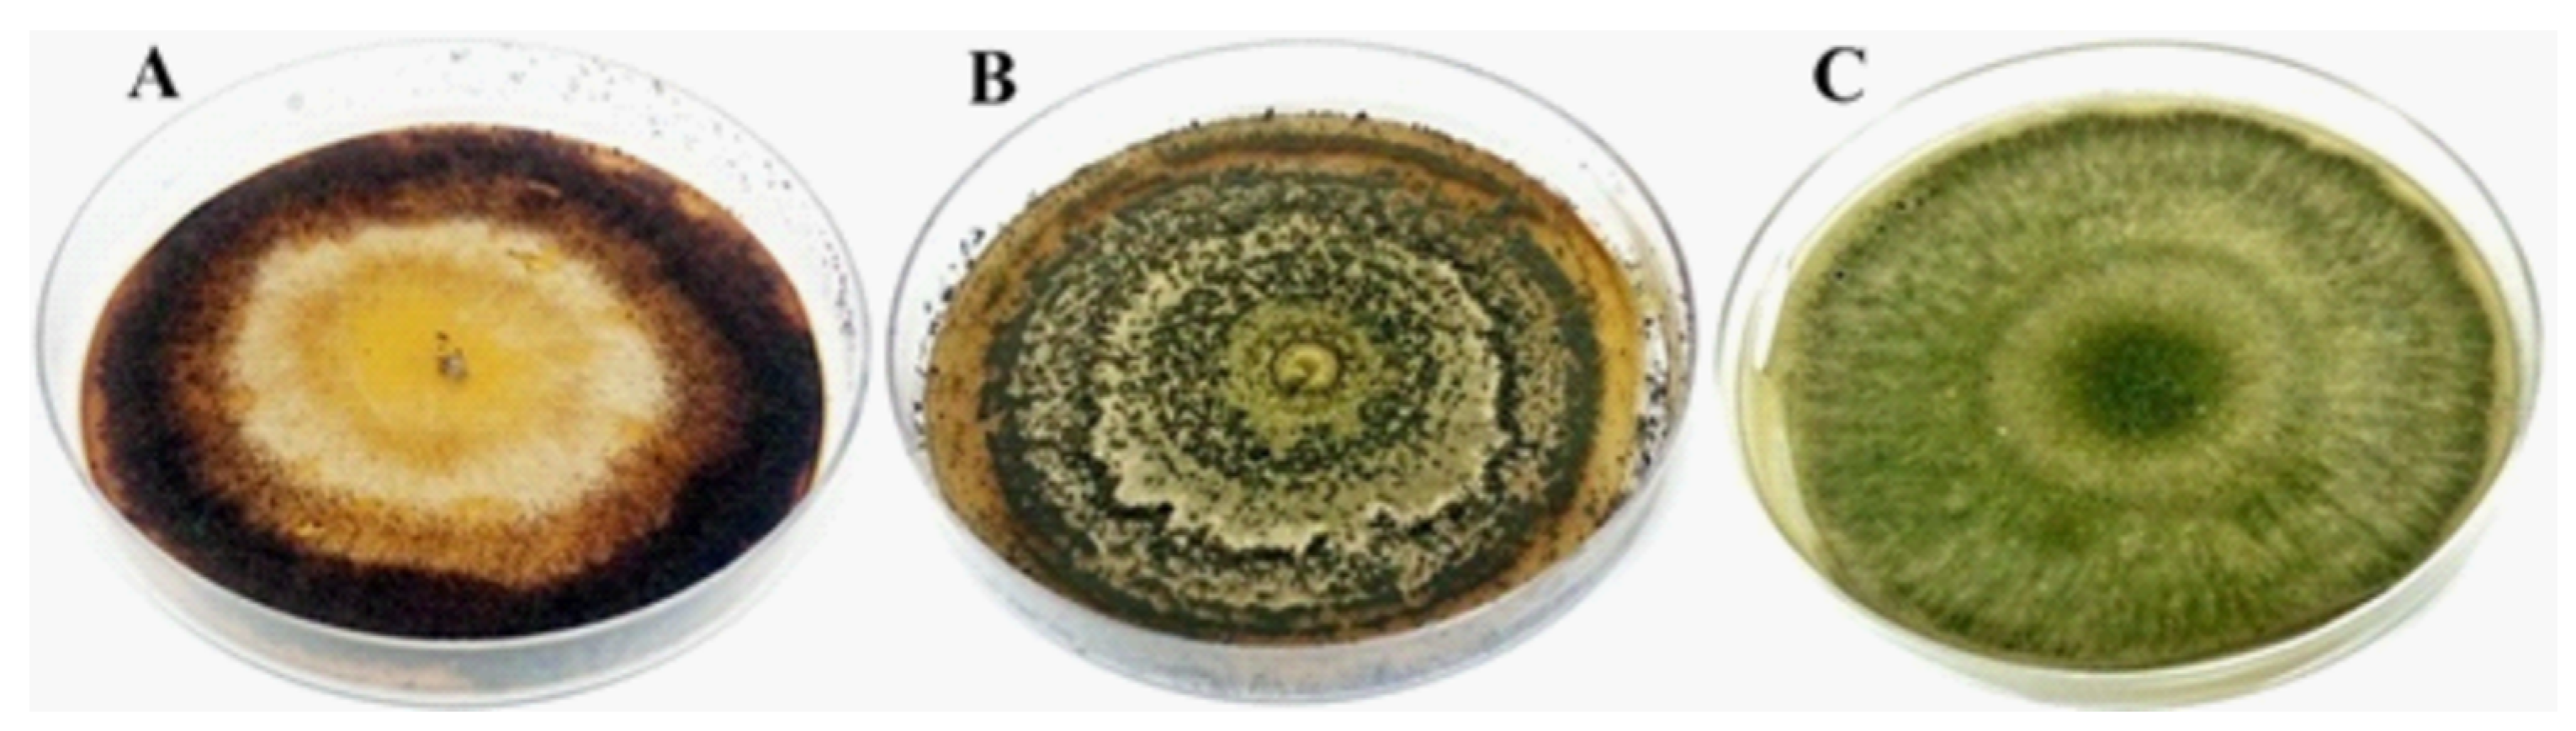
Jof 08 00015 g001

Effects of Trichoderma strigosellum in Eucalyptus urophylla Development and Leaf-Cutting Ant Behavior
Abstract
1. Introduction
2. Materials and Methods
2.1. Fungal Isolates and Monosporic Culture Preparation
2.2. Inoculum Preparation
2.3. Eucalyptus Seedling Production for Foliar Spray and Soil Drench Inoculation
2.4. Inoculation of E. urophylla Seedlings with Mycelium
2.5. Evaluation of Endophytic Colonization in Different Plant Organs
2.6. Assessment of Plant Biometric Characteristics
2.7. Maintenance of Atta Sexdens Colonies and Cut Behavior Assessment
2.8. Experimental Design and Statistical Analysis
3. Results
3.1. Endophytic Colonization
3.2. Biometric Characteristics
3.3. Foraging Behavior
3.4. Mechanisms of Plant Defense
4. Discussion
Author Contributions
Funding
Institutional Review Board Statement
Informed Consent Statement
Data Availability Statement
Acknowledgments
Conflicts of Interest
References
- IBÁ—Industria Brasileira de Árvores—Report 2019. Available online: https://iba.org/datafiles/publicacoes/relatorios/iba-relatorioanual2019.pdf (accessed on 23 September 2020).
- Della Lucia, T.M.; Gandra, L.C.; Guedes, R.N. Managing leaf-cutting ants: Peculiarities, trends and challenges. Pest Manag. Sci. 2014, 70, 14–23. [Google Scholar] [CrossRef] [PubMed]
- Della Lucia, T.M.C.; Amaral, K.D. Past and current strategies for the control of leaf-cutting ants in Brazil. In Forest Pest and Disease Management in Latin America—Modern Perspectives in Natural Forests and Exotic Plantations, 1st ed.; Estay, S., Ed.; Springer International Publishing: Cham, Switzerland, 2020; Volume 1, pp. 31–43. [Google Scholar]
- Schumacher, M.V.; Vieira, M. Silvicultura do Eucalipto no Brasil, 1st ed.; Editora UFSM: Santa Maria, Brazil, 2016; pp. 1–208. [Google Scholar]
- Della Lucia, T.M.C. Formigas-Cortadeiras: Da Bioecologia ao Manejo, 1st ed.; Editora da UFV: Viçosa, Brazil, 2011; pp. 1–421. [Google Scholar]
- Zanetti, R.; Zanuncio, J.C.; Santos, J.C.; da Silva, W.L.P.; Ribeiro, G.T.; Lemes, P.G. An overview of integrated management of leaf-cutting ants (Hymenoptera: Formicidae) in Brazilian forest plantations. Forests 2014, 5, 439–454. [Google Scholar] [CrossRef]
- Carreiro, S.C.; Pagnocca, F.C.; Bacci, M., Jr.; Lachance, M.-A.; Bueno, O.C.; Hebling, M.J.A.; Ruivo, C.C.C.; Rosa, C.A. Sympodiomyces attinorum sp. nov., a yeast species associated with nests of the leaf-cutting ant Atta sexdens. Int. J. Syst. Evol. Microbiol. 2004, 54, 1891–1894. [Google Scholar] [CrossRef] [PubMed]
- Santos, A.V.; Dillon, R.J.; Dillon, V.M.; Reynolds, S.E.; Samuels, R.I. Ocurrence of the antibiotic producing bacterium Burkholderia sp. in colonies of the leaf-cutting ant Atta sexdens rubropilosa. FEMS Microbiol. Lett. 2004, 239, 319–323. [Google Scholar] [CrossRef] [PubMed]
- Rodrigues, A.; Bacci, M., Jr.; Mueller, U.G.; Ortiz, A.; Pagnocca, F.C. Microfungal “weeds” in the leafcutter ant symbiosis. Microb. Ecol. 2008, 56, 604–614. [Google Scholar] [CrossRef] [PubMed]
- Nascimento, M.O.; Sarmento, R.A.; Santos, G.R.; Oliveira, C.A.; Souza, D.J. Antagonism of Trichoderma isolates against Leucoagaricus gongylophorus (Singer) Möller. J. Basic Microbiol. 2017, 57, 699–704. [Google Scholar] [CrossRef]
- Goffré, D.; Folgarait, P.J. Insights into the biodiversity and causes of distribution of potential entomopathogens associated with leaf-cutting ants. Insectes Soc. 2018, 65, 103–115. [Google Scholar] [CrossRef]
- Hughes, W.O.; Thomsen, L.; Eilenberg, J.; Boomsma, J.J. Diversity of entomopathogenic fungi near leaf-cutting ant nests in a neotropical forest, with particular reference to Metarhizium anisopliae var. anisopliae. J. Invertebr. Pathol. 2004, 85, 46–53. [Google Scholar] [CrossRef]
- Ribeiro, M.M.; Amaral, K.D.; Seide, V.E.; Souza, B.M.; Della Lucia, T.M.C.; Kasuya, M.C.M.; Souza, D.J. Diversity of fungi associated with Atta bisphaerica (Hymenoptera: Formicidae): The activity of Aspergillus ochraceus and Beauveria bassiana. Psyche 2012, 2012, 389806. [Google Scholar]
- Fisher, P.; Stradling, D.; Sutton, B.; Petrini, L. Microfungi in the fungus gardens of the leaf-cutting ant Atta cephalotes: A preliminary study. Mycol. Res. 1996, 100, 541–546. [Google Scholar] [CrossRef]
- Van Bael, S.A.; Fernández-Marín, H.; Valencia, M.C.; Rojas, E.I.; Wcislo, W.T.; Herre, E.A. Two fungal symbioses collide: Endophytic fungi are not welcome in leaf-cutting ant gardens. Proc. R. Soc. B 2009, 276, 2419–2426. [Google Scholar] [CrossRef]
- Bittleston, L.; Brockmann, F.; Wcislo, W.; Van Bael, S.A. Endophytic fungi reduce leaf-cutting ant damage to seedlings. Biol. Lett. 2011, 7, 30–32. [Google Scholar] [CrossRef] [PubMed]
- Coblentz, K.E.; Van Bael, S.A. Field colonies of leaf-cutting ants select plant materials containing low abundances of endophytic fungi. Ecosphere 2013, 4, 1–10. [Google Scholar] [CrossRef]
- Rocha, S.L.; Evans, H.C.; Jorge, V.L.; Cardoso, L.A.; Pereira, F.S.; Rocha, F.B.; Barreto, R.W.; Hart, A.G.; Elliot, S.L. Recognition of endophytic Trichoderma species by leaf-cutting ants and their potential in a Trojan-horse management strategy. R. Soc. Open Sci. 2017, 4, 160628. [Google Scholar] [CrossRef] [PubMed]
- Schulz, B.; Boyle, C.; Draeger, S.; Römmert, A.-K.; Krohn, K. Endophytic fungi: A source of novel biologically active secondary metabolites. Mycol. Res. 2002, 106, 996–1004. [Google Scholar] [CrossRef]
- Vinha, G.L.; Alcántara-de la Cruz, R.; Della Lucia, T.M.C.; Wilcken, C.F.; da Silva, E.D.; Lemes, P.G.; Zanuncio, J.C. Leaf-cutting ants in commercial forest plantations of Brazil: Biological aspects and control methods. South. For. 2020, 82, 95–103. [Google Scholar] [CrossRef]
- Mota-Filho, T.M.M.; Stefanelli, L.E.P.; Camargo, R.S.; de Matos, C.A.O.; Forti, L.C. Biological control in leaf-cutting ants, Atta sexdens (Hymenoptera: Formicidae), using pathogenic fungi. Rev. Arvore 2021, 45. [Google Scholar] [CrossRef]
- Daza, F.F.F.; Roman, G.R.; Rodriguez, M.V.; Vargas, I.R.G.; Heano, H.C.; Cereda, M.P.; Mulet, R.A.C. Spores of Beauveria bassiana and Trichoderma lignorum as a bioinsecticide for the control of Atta cephalotes. Biol. Res. 2019, 52, 51. [Google Scholar] [CrossRef] [PubMed]
- Schulz, B.; Boyle, C. What are endophytes? In Microbial Root Endophytes, 1st ed.; Schulz, B.J.E., Boyle, C.J.C., Sieber, T.N., Eds.; Springer: Berlin/Heidelberg, Germany, 2006; Volume 9, pp. 1–13. [Google Scholar]
- Estrada, C.; Wcislo, W.T.; Van Bael, S.A. Symbiotic fungi alter plant chemistry that discourages leaf-cutting ants. New Phytol. 2013, 198, 241–251. [Google Scholar] [CrossRef]
- Meister, B.; Krauss, J.; Härri, S.A.; Schneider, M.V.; Müller, C.B. Fungal endosymbionts affect aphid population size by reduction of adult life span and fecundity. Basic Appl. Ecol. 2006, 7, 244–252. [Google Scholar] [CrossRef]
- Poulsen, M.; Currie, C.R. Complexity of insect–fungal associations: Exploring the influence of microorganisms on attine the ant–fungus symbiosis. In Insect Symbiosis, 1st ed.; Bourtzis, K., Miller, T.A., Eds.; CRC Press: Boca Raton, FL, USA, 2006; Volume 2, pp. 79–100. [Google Scholar]
- Miller, J.D.; Mackenzie, S.; Foto, M.; Adams, G.W.; Findlay, J.A. Needles of white spruce inoculated with rugulosin-producing endophytes contain rugulosin reducing spruce budworm growth rate. Mycol. Res. 2002, 106, 471–479. [Google Scholar] [CrossRef]
- Nunes, A.; Santos, A.; Piotto, D.; Niella, G.; Medeiros, J.; Silva, G. Trichoderma spp. reveals potential as growth bio-promoter in forest seedlings. Agrotrópica 2021, 33, 17–28. [Google Scholar] [CrossRef]
- Macías-Rodríguez, L.; Contreras-Cornejo, H.A.; Adame-Garnica, S.G.; del Val, E.; Larsen, J. The interactions of Trichoderma at multiple trophic levels: Inter-kingdom communication. Microbiol. Res. 2020, 240, 126552. [Google Scholar] [CrossRef]
- Fernandez, M.R. Manual Para Laboratório de Fitopatologia, 1st ed.; Embrapa-Cnpt: Passo Fundo, Brazil, 1993; pp. 33–46. [Google Scholar]
- Parsa, S.; Ortiz, V.; Vega, F.E. Establishing fungal entomopathogens as endophytes: Towards endophytic biological control. JoVE 2013, e50360. [Google Scholar] [CrossRef] [PubMed]
- Schneider, C.; Rasband, W.; Eliceiri, K. NIH Image to ImageJ: 25 years of image analysis. Nat. Methods 2012, 9, 671–675. [Google Scholar] [CrossRef]
- Schaberg, P.G.; Murakami, P.F.; Turner, M.R.; Heitz, H.K.; Hawley, G.J. Associations between the red coloration and senescence of sugar maple leaves in autumn. Trees 2008, 22, 573. [Google Scholar] [CrossRef]
- Marsaro Júnior, A.; Molina-Rugama, A.; Lima, C.; Lucia, T.M.C. Preferência de corte de Eucalyptus spp. por Acromyrmex laticeps nigrosetosus Forel, 1908 (Hymenoptera: Formicidae) em condições de laboratório. Ciênc. Florest. 2007, 17, 171–174. [Google Scholar] [CrossRef]
- Cooley, J.R.; Hammond, G.S.; Morshol, P.D.C. Effects of enamel paint on the behavior and survival of the periodical cicada, Magicicada septendecim (Homoptera) and the lesser migratory grasshopper, Melanopws sanguinipes (Orthoptera). Great Lakes Entomol. 1998, 31, 161–168. [Google Scholar]
- Ferreira, D.F. Sisvar: A computer statistical analysis system. Cienc. Agrotec. 2011, 35, 1039–1342. [Google Scholar] [CrossRef]
- Pereira, G.V.N. Promoção do Crescimento de Mudas de Maracujazeiro Inoculadas com Trichoderma spp. Master of Science of UESB, Vitória da Conquista-Brazil, Bahia. 2012. Available online: http://www2.uesb.br/ppg/ppgagronomia/wp-content/uploads/2020/10/gleice-viviane.pdf (accessed on 11 November 2021).
- Ghimire, K.; Petrović, K.; Kontz, B.J.; Bradley, C.A.; Chilvers, M.I.; Mueller, D.S.; Smith, D.L.; Wise, K.A.; Mathew, F.M. Inoculation method impacts symptom development associated with Diaporthe aspalathi, D. caulivora, and D. longicolla on soybean (Glycine max). Plant Dis. 2018, 103, 677–684. [Google Scholar] [CrossRef] [PubMed]
- Bailey, B.; Bae, H.; Strem, M.; Roberts, D.; Thomas, S.; Crozier, J.; Samuels, G.J.; Choi, I.-Y.; Holmes, K.A. Fungal and plant gene expression during the colonization of cacao seedlings by endophytic isolates of four Trichoderma species. Planta 2006, 224, 1449–1464. [Google Scholar] [CrossRef]
- Metcalf, D.; Wilson, C. The process of antagonism of Sclerotium cepivorum in white rot affected onion roots by Trichoderma koningii. Plant Pathol. 2001, 50, 249–257. [Google Scholar] [CrossRef]
- Azevedo, G.B.; Novaes, Q.S.; Azevedo, G.O.; Silva, H.F.; Sobrinho, G.G.R.; Novaes, A.B. Effect of Trichoderma spp. on Eucalyptus camaldulensis clonal seedlings growth. Sci. For. 2017, 45, 343–352. [Google Scholar] [CrossRef]
- Filho, M.R.C.; Martins, I.; Peixoto, G.; Muniz, P.C.; Carvalho, D.; Mello, S.C.M. Biological control of leaf spot and growth promotion of Eucalyptus plants by Trichoderma spp. J. Agric. Sci. 2018, 10, 459–467. [Google Scholar] [CrossRef][Green Version]
- Owen, N.L.; Hundley, N. Endophytes—The chemical synthesizers inside plants. Sci. Prog. 2004, 87, 79–99. [Google Scholar] [CrossRef]
- Sieber, T.N. Endophytic fungi in forest trees: Are they mutualists? Fungal Biol. Rev. 2007, 21, 75–89. [Google Scholar] [CrossRef]
- Kessler, P.; Matzke, H.; Keller, S. The effect of application time and soil factors on the occurrence of Beauveria brongniartii applied as a biological control agent in soil. J. Invertebr. Pathol. 2003, 84, 15–23. [Google Scholar] [CrossRef]
- Tefera, T.; Vidal, S. Effect of inoculation method and plant growth medium on endophytic colonization of sorghum by the entomopathogenic fungus Beauveria bassiana. BioControl 2009, 54, 663–669. [Google Scholar] [CrossRef]
- Heine, D.; Holmes, N.A.; Worsley, S.F.; Santos, A.C.A.; Innocent, T.M.; Scherlach, K.; Patrick, E.H.; Yu, D.W.; Murrell, J.C.; Vieria, P.C.; et al. Chemical warfare between leafcutter ant symbionts and a co-evolved pathogen. Nat. Commun. 2018, 9, 2208. [Google Scholar] [CrossRef]
- Salgado, A.P.S.P.; Cardoso, M.G.; Souza, P.E.; Souza, J.A.; Abreu, C.M.P.; Pinto, J.E.B. Avaliação da atividade fungitóxica de óleos essenciais de folhas de Eucalyptus sobre Fusarium oxysporum, Botrytis cinerea e Bipolaris sorokiniana. Cienc. Agrotecnol. 2003, 27, 249–254. [Google Scholar] [CrossRef]
- Coley, P.D.; Barone, J. Herbivory and plant defenses in tropical forests. Annu. Rev. Ecol. Evol. Syst. 1996, 27, 305–335. [Google Scholar] [CrossRef]
- Romão-Dumaresq, A.S.; Dourado, M.N.; Fávaro, L.C.L.; Mendes, R.; Ferreira, A.; Araujo, W.L. Diversity of cultivated fungi associated with conventional and transgenic sugarcane and the interaction between endophytic Trichoderma virens and the host plant. PLoS ONE 2016, 11, e0158974. [Google Scholar] [CrossRef]
- Benítez, T.; Rincón, A.M.; Limón, M.C.; Codon, A.C. Biocontrol mechanisms of Trichoderma strains. Int. Microbiol. 2004, 7, 249–260. [Google Scholar] [PubMed]
- Stewart, A.; Hill, R. Applications of Trichoderma in plant growth promotion. In Biotechnology and Biology of Trichoderma; Elsevier: Amsterdam, The Netherlands, 2014; pp. 415–428. [Google Scholar] [CrossRef]
- Harman, G.E.; Howell, C.R.; Viterbo, A.; Chet, I.; Lorito, M. Trichoderma species—Opportunistic, avirulent plant symbionts. Nat. Rev. Microbiol. 2004, 2, 43–56. [Google Scholar] [CrossRef]
- Altomare, C.; Norvell, W.; Björkman, T.; Harman, G. Solubilization of phosphates and micronutrients by the plant-growth-promoting and biocontrol fungus Trichoderma harzianum Rifai 1295-22. Appl. Environ. Microbiol. 1999, 65, 2926–2933. [Google Scholar] [CrossRef] [PubMed]
- Baker, R. Induction of rhizosphere competence in the biocontrol fungus Trichoderma. In The Rhizosphere and Plant Growth; Springer: Dordrecht, The Netherlands, 1991; pp. 221–228. [Google Scholar] [CrossRef]
- Rocha, S.L.; Jorge, V.L.; Della Lucia, T.M.; Barreto, R.W.; Evans, H.C.; Elliot, S.L. Quality control by leaf-cutting ants: Evidence from communities of endophytic fungi in foraged and rejected vegetation. Arthropod Plant Interact. 2014, 8, 485–493. [Google Scholar] [CrossRef]
- Karageorgou, P.; Buschmann, C.; Manetas, Y. Red leaf color as a warning signal against insect herbivory: Honest or mimetic? Flora Morphol. Distrib. Funct. Ecol. Plants 2008, 203, 648–652. [Google Scholar] [CrossRef]
- Maskato, Y.; Talal, S.; Keasar, T.; Gefen, E. Red foliage color reliably indicates low host quality and increased metabolic load for development of an herbivorous insect. Arthropod Plant Interact. 2014, 8, 285–292. [Google Scholar] [CrossRef]
- Muiruri, E.W.; Barantal, S.; Iason, G.R.; Salminen, J.P.; Perez-Fernandez, E.; Koricheva, J. Forest diversity effects on insect herbivores: Do leaf traits matter? New Phytol. 2019, 221, 2250–2260. [Google Scholar] [CrossRef]
- Schaefer, H.M.; Rolshausen, G. Plants on red alert: Do insects pay attention? BioEssays 2006, 28, 65–71. [Google Scholar] [CrossRef]
- Peeters, P.J.; Sanson, G.; Read, J. Leaf biomechanical properties and the densities of herbivorous insect guilds. Funct. Ecol. 2007, 21, 246–255. [Google Scholar] [CrossRef]
- Chen, Y.Z.; Huang, S.Q. Red young leaves have less mechanical defence than green young leaves. Oikos 2013, 122, 1035–1041. [Google Scholar] [CrossRef]

| Inoculation Methods | Fungi | Plant Organs | ||
|---|---|---|---|---|
| Leaves | Stem | Roots | ||
| Foliar spray | Control | 0 | 0 | 0 |
| Escovopsis sp. | 0 | 0 | 0 | |
| Metarhizium anisopliae | 0 | 0 | 0 | |
| Trichoderma strigosellum | 0 | 0 | 0 | |
| Soil drench | Control | 0 | 0 | 0 |
| Escovopsis sp. | 0 | 0 | 0 | |
| Metarhizium anisopliae | 0 | 0 | 0 | |
| Trichoderma strigosellum | 0 | 60% | 50% | |
| Seedlings with mycelium | Control | 0 | 0 | 0 |
| Escovopsis sp. | - | - | - | |
| Metarhizium anisopliae | 0 | 0 | 0 | |
| Trichoderma strigosellum | 60% | 70% | 90% | |
| Traits | Source of Variation | Mean | C.V. (%) | |||
|---|---|---|---|---|---|---|
| Inoculation Methods (M) | Fungal Species (F) | M × F | Residual | |||
| Degrees of Freedom | ||||||
| 2 | 3 | 6 | 48 | |||
| Plant height | 1045.71 * | 1261.35 * | 886.58 * | 35.15 | 42.88 | 13.83 |
| Number of leaves | 11.31 ns | 198.28 * | 217.98 * | 15.4 | 15.08 | 26.02 |
| Shoot dry mass | 0.03 ns | 0.85 * | 0.82 * | 0.1 | 1.00 | 31.77 |
| Root dry mass | 0.01 ns | 0.01 ns | 0.05 * | 0 | 0.22 | 41.34 |
| Total dry mass | 0.09 ns | 1.06 * | 1.26 * | 0.15 | 1.23 | 31.50 |
Publisher’s Note: MDPI stays neutral with regard to jurisdictional claims in published maps and institutional affiliations. |
© 2021 by the authors. Licensee MDPI, Basel, Switzerland. This article is an open access article distributed under the terms and conditions of the Creative Commons Attribution (CC BY) license (https://creativecommons.org/licenses/by/4.0/).
Share and Cite
Batista, K.O.M.; Silva, D.V.; Nascimento, V.L.; de Souza, D.J. Effects of Trichoderma strigosellum in Eucalyptus urophylla Development and Leaf-Cutting Ant Behavior. J. Fungi 2022, 8, 15. https://doi.org/10.3390/jof8010015
Batista KOM, Silva DV, Nascimento VL, de Souza DJ. Effects of Trichoderma strigosellum in Eucalyptus urophylla Development and Leaf-Cutting Ant Behavior. Journal of Fungi. 2022; 8(1):15. https://doi.org/10.3390/jof8010015
Chicago/Turabian StyleBatista, Kamilla Otoni Marques, Dayara Vieira Silva, Vitor L. Nascimento, and Danival José de Souza. 2022. "Effects of Trichoderma strigosellum in Eucalyptus urophylla Development and Leaf-Cutting Ant Behavior" Journal of Fungi 8, no. 1: 15. https://doi.org/10.3390/jof8010015
APA StyleBatista, K. O. M., Silva, D. V., Nascimento, V. L., & de Souza, D. J. (2022). Effects of Trichoderma strigosellum in Eucalyptus urophylla Development and Leaf-Cutting Ant Behavior. Journal of Fungi, 8(1), 15. https://doi.org/10.3390/jof8010015

